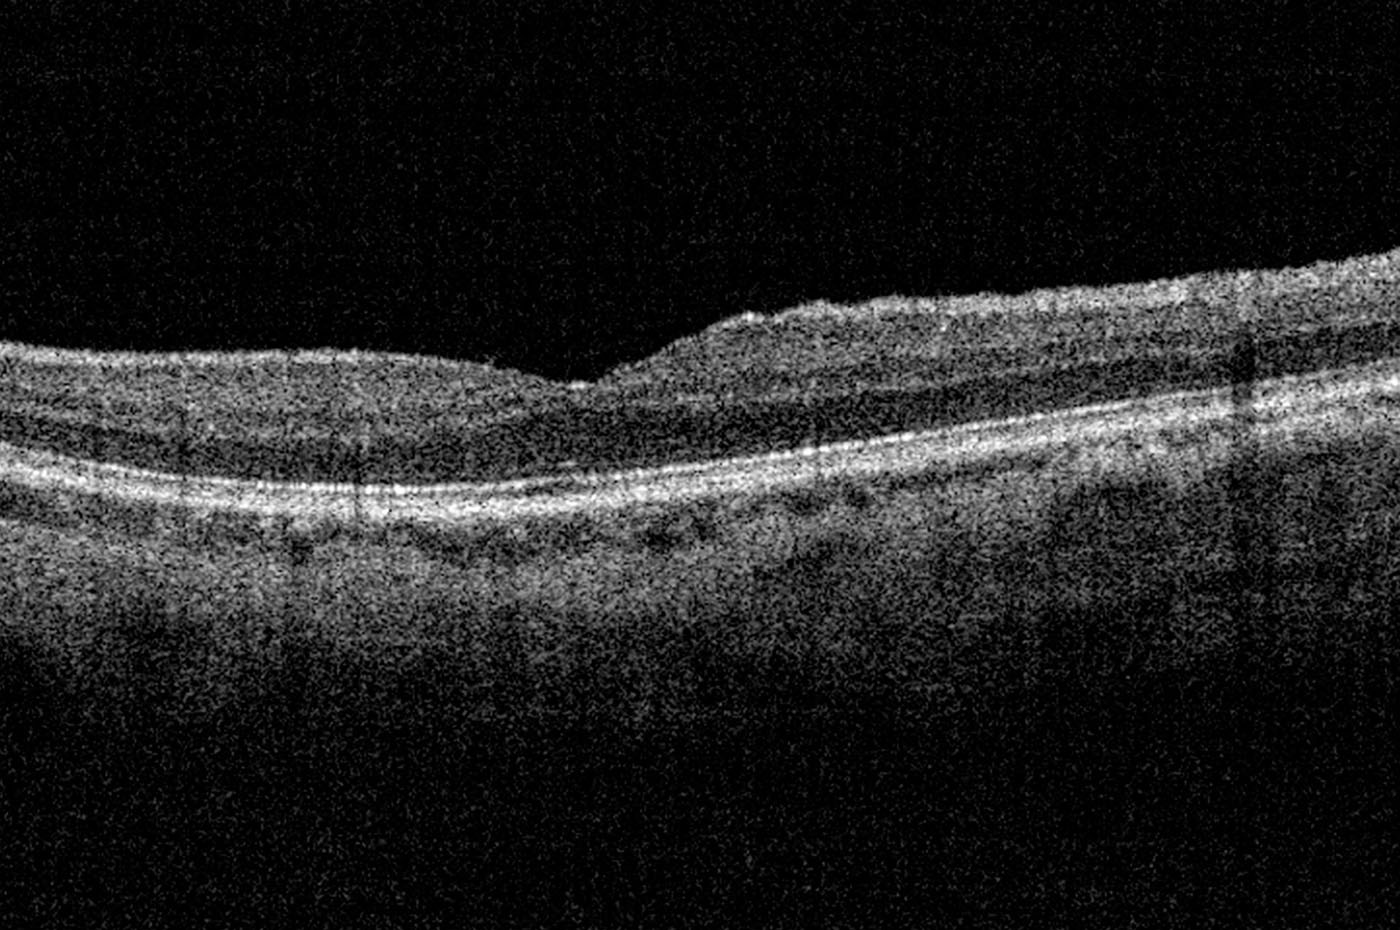

© 2020 Ezequiel Bluvstein
Ex-Traditio
En la década de 1950, cuando todavía no habían cumplido los 20 años, mis padres estuvieron a punto de emigrar a Israel y cumplir el gran sueño sionista con el que habían crecido. Sin embargo, a último momento cambiaron de planes y no lo hicieron. Esa decisión, un poco heroica un poco cobarde, los acompañó el resto de sus vidas y marcó la mía.
Ex-Traditio indaga en estos matices incómodos de la historia familiar, y plantea una reflexión en torno al carácter conflictivo subyacente en la mayoría de las tradiciones. Es, ante todo, un proyecto sobre la frustración.
*Seleccionado en Descubrimientos PhotoEspaña 2021.
*Expuesto en el 6º y 7º Nano Festival de Fotografía, FoLa (fragmentos).
*Expuesto en el 6º y 7º Nano Festival de Fotografía, FoLa (fragmentos).